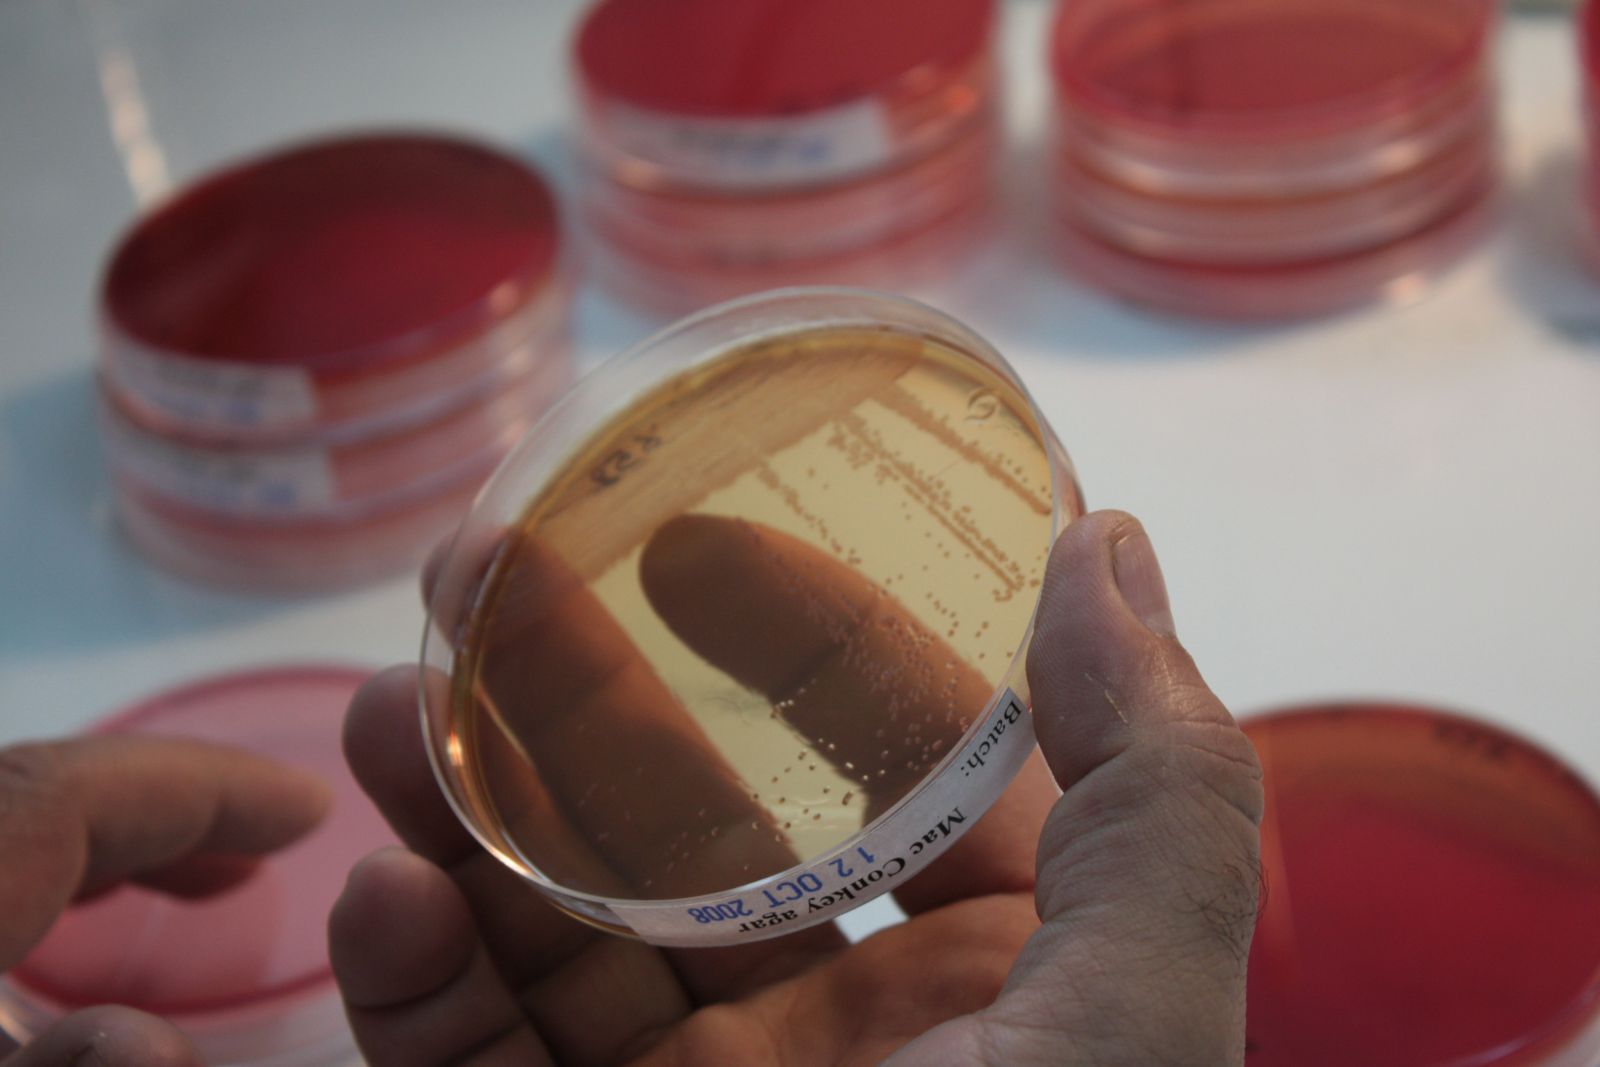

Mali : un nouveau laboratoire de bactériologie à l’hôpital de Koutiala

Depuis décembre 2013, MSF restructure et rénove le laboratoire central de l’hôpital de Koutiala, au Mali, où elle gère l’unité pédiatrique. Le nouveau laboratoire sera doté d’un département de bactériologie qui permettra de diagnostiquer toutes les pathologies bactériennes de la petite enfance. Une première pour MSF sur un programme long terme.Entretien avec Jean-Baptiste Ronat, référent laboratoire au siège de MSF
Pourquoi construire un département de bactériologie ?
Jean-Baptiste Ronat : L’objectif est d’améliorer les diagnostics effectués au laboratoire afin de répondre aux exigences de qualité de la prise en charge médicale au niveau de l’hôpital. Grâce au département de bactériologie, MSF sera en mesure de diagnostiquer toutes les pathologies bactériennes dont sont atteints les enfants. Chez les enfants sévèrement malnutris, 30% de la mortalité est liée à des septicémies (des infections du sang) dont on ne connaissait pas la cause. Grâce à la bactériologie, nous pourrons désormais cultiver les bactéries pour identifier la cause de la septicémie chez l’enfant et proposer un traitement adapté grâce aux antibiogrammes.
 A quoi sert un antibiogramme ?
A quoi sert un antibiogramme ?
J.B.R : L’antibiogramme est un examen bactériologique qui permet au médecin de sélectionner et de choisir le meilleur antibiotique permettant de traiter efficacement le patient. Il s’agit de tester la sensibilité d'une souche bactérienne vis-à-vis d'un ou plusieurs antibiotiques supposés ou connus. Le principe consiste à placer la culture de bactéries en présence du ou des antibiotiques et à observer les conséquences sur le développement et la survie de celle-ci. Les enfants bénéficieront ainsi d’un traitement ciblé qui assurera une guérison plus rapide et réduira ainsi le nombre de jours d’hospitalisation. L’autre avantage, c’est que le traitement antibiotique mis au point suite à l’analyse par antibiogramme contribuera à diminuer le développement de souches résistantes.
Quels sont les problèmes posés par la résistance aux antibiotiques ?
J.B.R : La résistance aux antibiotiques est un enjeu crucial pour les années à venir. Dans un futur proche, les gens pourraient mourir de maladies bénignes comme une bronchite ou une angine parce que les antibiotiques seront devenus inopérants. Au contact des antibiotiques, les bactéries, en mutant, acquièrent des gènes de résistance. C’est pour cela qu’il faut absolument cibler le bon antibiotique, celui qui tuera la bactérie. Si la bactérie résiste à l’antibiotique, elle se multipliera et facilitera l’émergence de germes résistants. Il faut absolument pousser la recherche et l’innovation dans ce domaine. Le laboratoire participe à cet effort.
J.B.R : La résistance aux antibiotiques est un enjeu crucial pour les années à venir. Dans un futur proche, les gens pourraient mourir de maladies bénignes comme une bronchite ou une angine parce que les antibiotiques seront devenus inopérants. Au contact des antibiotiques, les bactéries, en mutant, acquièrent des gènes de résistance. C’est pour cela qu’il faut absolument cibler le bon antibiotique, celui qui tuera la bactérie. Si la bactérie résiste à l’antibiotique, elle se multipliera et facilitera l’émergence de germes résistants. Il faut absolument pousser la recherche et l’innovation dans ce domaine. Le laboratoire participe à cet effort.
Comment sera organisé le futur laboratoire ?
J.B.R : Les autres services du laboratoire seront organisés au sein du département principal et de la banque de sang. Le département "principal" sera notamment en charge des analyses dites "conventionnelles" comme la biochimie, l’hématologie (étude du sang, des maladies du sang) et le dépistage du sida. La banque de sang sera équipée avec du matériel de qualité pour répondre aux besoins de transfusions de l’ensemble de l’hôpital (près de 6 000 perfusions par an). MSF souhaite également mettre en place un système de don bénévole de sang avec l’appui d’associations locales. L’enjeu est de fidéliser des donneurs au sein des communautés locales.
Quel est l’objectif de MSF pour ce laboratoire ?
J.B.R : L’ambition pour MSF est que ce laboratoire devienne un centre de formation pour les techniciens de laboratoire de MSF basés dans d’autres pays ainsi que pour le personnel du ministère de la Santé malien. Aux mois de juin et septembre prochains, nous recevrons entre 6 et 10 stagiaires d’écoles de laborantins. Destiné à devenir un véritable centre de référence dans le contrôle qualité, le laboratoire servira aussi de support pour la recherche médicale sur les cas de malnutrition sévère et la surveillance de la résistance bactérienne au sein de la population.
Les travaux de construction du laboratoire débutés en décembre 2013 devraient s’achever fin février 2014. Ils sont supervisés localement par un architecte envoyé par MSF. Le nouveau laboratoire aura une superficie de 190 m2 dont 70m2 pour le nouveau département de bactériologie. Le budget global de ce projet s’élève à 96 000 euros, dont 60 000 euros pour la construction et 36 000 euros pour l’achat des équipements et des machines.
Rappel de l’activité de MSF à Koutiala
Depuis 2009, MSF mène avec le ministère malien de la Santé un projet de soins pédiatriques à Koutiala dans la région de Sikasso. L’objectif de ce projet est de définir un ensemble minimum de soins gratuits pédiatriques pour réduire le nombre de patients nécessitant une hospitalisation, permettre une croissance harmonieuse et éviter un grand nombre de décès précoces. À l’hôpital de Koutiala, MSF gère une unité pédiatrique, dont la capacité peut atteindre 300 lits lors du pic saisonnier. MSF soutient également l’accès aux soins primaires gratuits dans cinq centres de santé périphériques et transfère les cas les plus sévères à l’hôpital.


